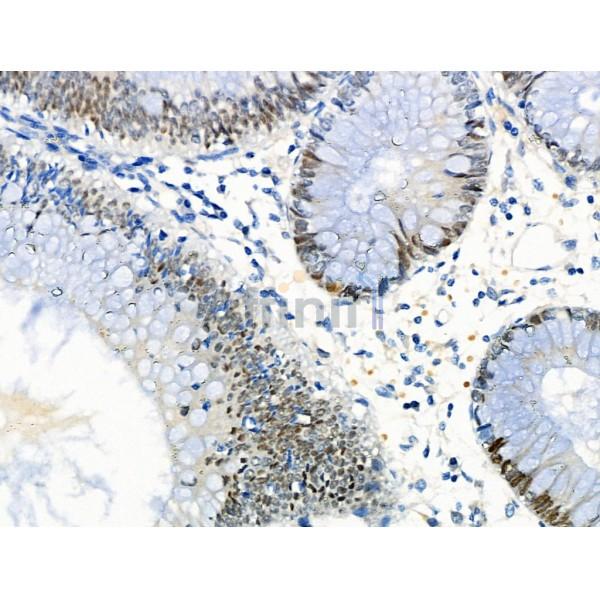
LRRC41 Antibody - DF4138 at 1/100 staining Human colorectal cancer and adjacent normal tissues by IHC-P.

LRRC41 Antibody - #DF4138
| Product: | LRRC41 Antibody |
| Catalog: | DF4138 |
| Description: | Rabbit polyclonal antibody to LRRC41 |
| Application: | WB IHC IF/ICC |
| Reactivity: | Human, Mouse, Rat |
| Prediction: | Pig, Bovine, Horse, Sheep, Rabbit, Dog |
| Mol.Wt.: | 80 KD; 89kD(Calculated). |
| Uniprot: | Q15345 |
| RRID: | AB_2836503 |
Related Downloads
Protocols
Product Info
*The optimal dilutions should be determined by the end user. For optimal experimental results, antibody reuse is not recommended.
*Tips:
WB: For western blot detection of denatured protein samples. IHC: For immunohistochemical detection of paraffin sections (IHC-p) or frozen sections (IHC-f) of tissue samples. IF/ICC: For immunofluorescence detection of cell samples. ELISA(peptide): For ELISA detection of antigenic peptide.
Cite Format: Affinity Biosciences Cat# DF4138, RRID:AB_2836503.
Fold/Unfold
elongin BC interacting leucine rich repeat protein; Leucine rich repeat containing 41; Leucine rich repeat containing protein 41; MUF1; PP7759;
Immunogens
A synthesized peptide derived from human LRRC41, corresponding to a region within the internal amino acids.
- Q15345 LRC41_HUMAN:
- Protein BLAST With
- NCBI/
- ExPASy/
- Uniprot
MAAPEAWRARSCWFCEVAAATTMEATSREAAPAKSSASGPNAPPALFELCGRAVSAHMGVLESGVWALPGPILQSILPLLNIYYLERIEETALKKGLSTQAIWRRLWDELMKTRPSSLESVTCWRAKFMEAFFSHVLRGTIDVSSDRRLCDQRFSPLLHSSRHVRQLTICNMLQGATELVAEPNRRVLETLASSLHTLKFRHLLFSDVAAQQSLRQLLHQLIHHGAVSQVSLYSWPVPESALFILILTMSAGFWQPGPGGPPCRLCGEASRGRAPSRDEGSLLLGSRRPRRDAAERCAAALMASRRKSEAKQMPRAAPATRVTRRSTQESLTAGGTDLKRELHPPATSHEAPGTKRSPSAPAATSSASSSTSSYKRAPASSAPQPKPLKRFKRAAGKKGARTRQGPGAESEDLYDFVFIVAGEKEDGEEMEIGEVACGALDGSDPSCLGLPALEASQRFRSISTLELFTVPLSTEAALTLCHLLSSWVSLESLTLSYNGLGSNIFRLLDSLRALSGQAGCRLRALHLSDLFSPLPILELTRAIVRALPLLRVLSIRVDHPSQRDNPGVPGNAGPPSHIIGDEEIPENCLEQLEMGFPRGAQPAPLLCSVLKASGSLQQLSLDSATFASPQDFGLVLQTLKEYNLALKRLSFHDMNLADCQSEVLFLLQNLTLQEITFSFCRLFEKRPAQFLPEMVAAMKGNSTLKGLRLPGNRLGNAGLLALADVFSEDSSSSLCQLDISSNCIKPDGLLEFAKRLERWGRGAFGHLRLFQNWLDQDAVTAREAIRRLRATCHVVSDSWDSSQAFADYVSTM
Predictions
Score>80(red) has high confidence and is suggested to be used for WB detection. *The prediction model is mainly based on the alignment of immunogen sequences, the results are for reference only, not as the basis of quality assurance.
High(score>80) Medium(80>score>50) Low(score<50) No confidence
Research Backgrounds
Probable substrate recognition component of an ECS (Elongin BC-CUL2/5-SOCS-box protein) E3 ubiquitin ligase complex which mediates the ubiquitination and subsequent proteasomal degradation of target proteins.
The Elongin BC complex binding domain is also known as BC-box with the consensus [APST]-L-x(3)-C-x(3)-[AILV].
Restrictive clause
Affinity Biosciences tests all products strictly. Citations are provided as a resource for additional applications that have not been validated by Affinity Biosciences. Please choose the appropriate format for each application and consult Materials and Methods sections for additional details about the use of any product in these publications.
For Research Use Only.
Not for use in diagnostic or therapeutic procedures. Not for resale. Not for distribution without written consent. Affinity Biosciences will not be held responsible for patent infringement or other violations that may occur with the use of our products. Affinity Biosciences, Affinity Biosciences Logo and all other trademarks are the property of Affinity Biosciences LTD.